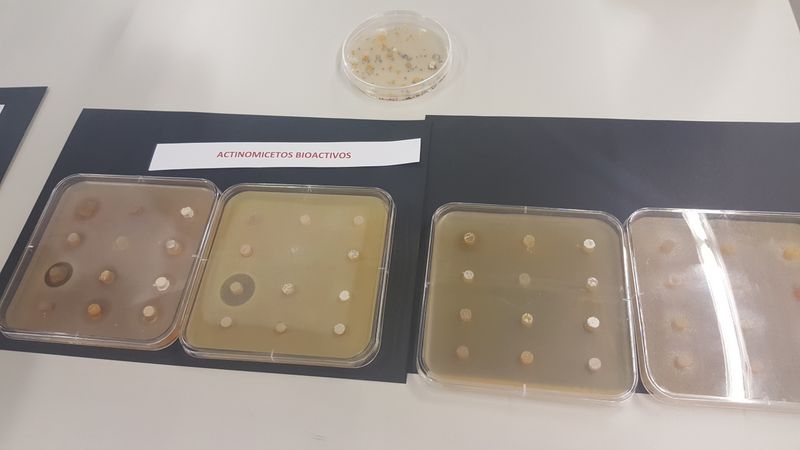
Alumnos de biología en el IBFG Alumnos de biología en el IBFG
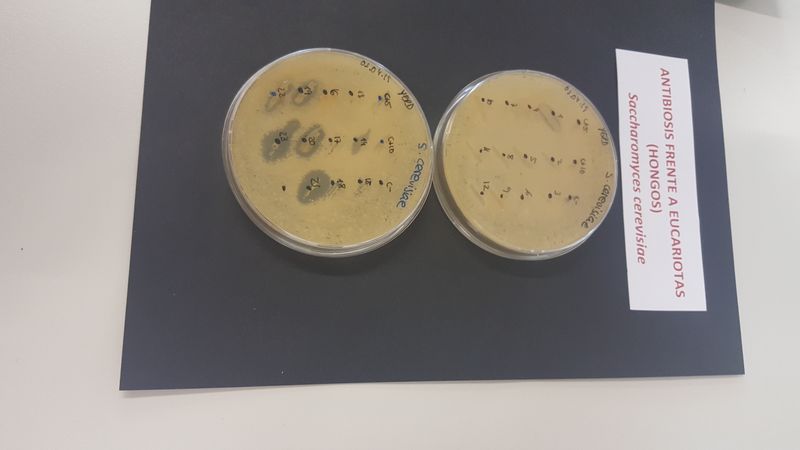
Alumnos de biología en el IBFG Alumnos de biología en el IBFG

Alumnos de biología en el IBFG
Los alumnos de biología de 1º bachillerato visitan el IBFG.
Las siglas IBFG representan al Instituto de Biología Funcional y Genómica, un centro mixto de investigación que comparten el Centro Superior de Investigaciones Científicas (CSIC) y la Universidad de Salamanca.
Hasta allí se desplazaron los alumnos de Biología de 1º bachillerato para conocer los diferentes departamentos y dependencias, su estructura y funcionamiento.
Conocieron los experimentos y les explicaron las líneas de investigación:
- Morfogénesis y polaridad celular.
- Dinámica del genoma y epigenética.
- Regulación génica y diferenciación celular.
Esta visita tan interesante despertó en alguno de nuestros alumnos la curiosidad por la investigación.
VOLVER